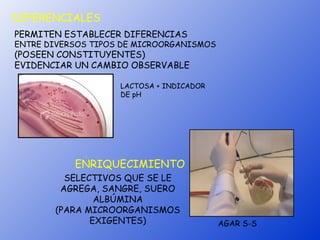
DIFERENCIALES
PERMITEN ESTABLECER DIFERENCIAS
ENTRE DIVERSOS TIPOS DE MICROORGANISMOS
(POSEEN CONSTITUYENTES)
EVIDENCIAR UN CAMBIO OBSERVABLE

                    LACTOSA + INDICADOR
                    DE pH




           ENRIQUECIMIENTO
         SELECTIVOS QUE SE LE
        AGREGA, SANGRE, SUERO
               ALBÚMINA
       (PARA MICROORGANISMOS
              EXIGENTES)                  AGAR S-S

El documento describe la fisiología y el metabolismo bacteriano. Explica que permite entender el modo de vida y hábitat de las bacterias, formular medios de cultivo y conocer el modo de acción de los antimicrobianos. Describe los procesos metabólicos como la fermentación, respiración y cadena transportadora de electrones, así como los requerimientos nutricionales de las bacterias como fuentes de carbono, energía y electrones.